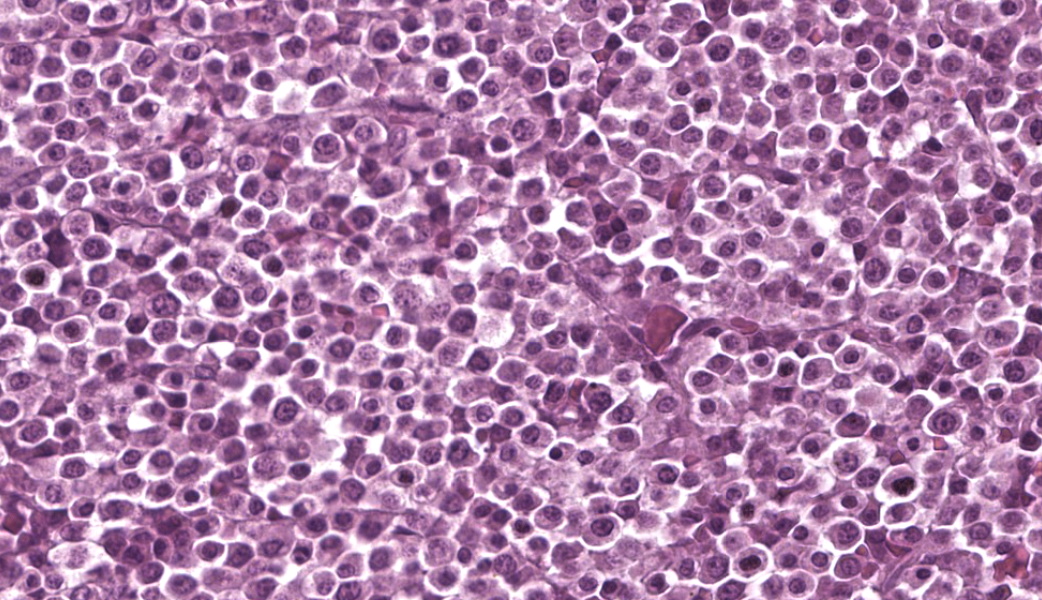

Case 1:
Signalment:
5-year-old, neutered male, domestic ferret (Mustela putorius furo)
History:
The patient was presented to the Exotics Service for evaluation of acute non-ambulatory paraparesis. The patient had a more prolonged history of lethargy and diarrhea. Neurolocalization was to the T3-L3 spinal cord. On abdominal palpation, the bladder was markedly distended and turgid; the spleen was severely enlarged, and multiple abdominal lymph nodes were enlarged. Cytology of the spleen showed moderate plasmacytosis and extramedullary hematopoiesis. The owners elected euthanasia due to concerns for quality of life.
Gross Pathology:
Associated with the vertebral body and the ventral aspects of the pedicles of T11 and protruding into the vertebral canal was a 0.6 cm long, soft, light purple grey, bilobed mass that surrounded and compressed the local segment of spinal cord. With examination of the external surface, an approximately 1.4 cm long segment of the regional spinal cord was streaked white, red, and dark red (hemorrhages). After formalin fixation and decalcification, the T11-L1 vertebrae was sectioned serially. The cut surfaces of the T11 vertebral body and portions of the pedicles were expanded and replaced by a poorly demarcated, soft, shiny, white tissue inconsistently mantled by an irregular brown rim that filled the medullary cavity with loss of the trabecular architecture. The regional cortical bone was irregular and multifocally thinned.
In addition, the spleen was severely enlarged (95.6 g; 6.8% of the body weight) with dozens of randomly distributed sharply demarcated, pinpoint to 0.6 cm in diameter, oval to spherical, soft, white foci and nodules.
Laboratory Results:
Pertinent Hematology and Biochemistry:
RBC - 11.94 M/uL (6.60 - 12.20 M/uL)
Calcium - 11.5 mg/dL (7.6 - 10.4 mg/dL)
Total Protein - 8.7 g/dL (4.8 - 8.3 g/dL)
Albumin - 3.6 g/dL (2.6 - 4.0 g/dL)
Globulin - 5.1 g/dL (2.2 - 4.3 g/dL)
Albumin: Globulin Ratio - 0.7
Cholesterol - 126 mg/dL (100 - 300 mg/dL)
Urine Protein Electrophoresis:
At the time of euthanasia, urine protein electrophoresis (IDEXX Diagnostic Laboratories) was pending. The following day, a large peak in the beta fraction (284.74 mg/dL) that appears relatively narrow supporting a possible monoclonal gammopathy was reported. Urine electrophoretograms are best interpreted in correlation with serum electrophoresis to confirm monoclonal gammopathy.
Urine Protein - 340.6 mg/dL
Albumin (EPH) - 11.24 mg/dL
Alpha Globulin % - 27.59 mg/dL
Beta Globulin - 284.74 mg/dL
Gamma Globulin - 17.03 mg/dL
Postmortem Cytology:
Vertebral foramen mass Touch imprints of the surface of the T11 vertebral canal mass are composed of sheets of markedly pleomorphic neoplastic round cells. Round cells have moderate to large amounts of deep to pale blue cytoplasm with variable nuclear-to-cytoplasmic ratio. These cells typically contain a single, eccentrically marked cellular and nuclear pleomorphism. There are rare atypical mitotic figures.
Microscopic Description:
T11 Vertebra: Replacing and effacing the medullary cavity and multifocally infiltrating and destroying the cortical bone to extend into the vertebral foramen and local paravertebral stroma is a densely cellular, unencapsulated, poorly demarcated, infiltrative mass comprised of closely packed round cells arranged in sheets supported by a fine, fibrovascular stroma. Neoplastic round cells have distinct cell borders, moderate amounts of pale eosinophilic cytoplasm with inconsistent perinuclear clearing (Golgi apparatus), and single nucleus. Nuclei are round, paracentral to eccentric, and have coarse to clumped chromatin and up to one prominent nucleolus. Anisocytosis and anisokaryosis are marked, with up to 6-fold difference in nuclear side, as well as occasional megakaryocytic cells and bi- and multinucleated neoplastic cells. Fifteen mitotic figures are seen in 10 [40x x FN22] HPF. Infrequent individual necrotic neoplastic cells are scattered throughout the tumor. Approximately 40% of the vertebral cortical bone is lytic due to tumor infiltration and is multifocally replaced by reactive fibroblasts and a fibrocollagenous stroma. The retained cortical bone is multifocally thinned and there is resorption and remodeling characterized by scalloped surfaces and shelves of woven bone bordered by neoplastic cells and reactive fibroblasts. At the periphery of the tumor and within regions of bone resorption there are minimal hemorrhages.
Contributor's Morphologic Diagnoses:
T11 VERTEBRA, MASS REGION: Malignant plasma cell tumor (multiple myeloma/plasma cell myeloma) with regional cortical bone, skeletal muscle, and adipose tissue invasion; bone loss, resorption, and remodeling; and myelophthisis [mitotic count = 15 mitotic figures in 10 [40x x FN22] HPF]
SPINAL CORD, T11 REGION (slide not included):
- Hemorrhages, acute, multifocal to coalescing, moderate
- Axonal degeneration, multifocal to coalescing (ventral and lateral funiculi), severe with markedly dilated myelin sheaths, multifocal intravacuolar fragmented myelin and macrophages (ellipsoids/digestion chambers); multifocal swollen axons (spheroids); and marked reactive glial cells [compression myelopathy]
SPLEEN (slide not included):
- Multifocal to coalescing malignant plasma cell tumors (multiple myeloma/plasma cell myeloma), multifocal with atypia [mitotic count = 11 mitotic figures in 10 [40x x FN22] HPF]
- Extramedullary hematopoiesis, chronic, multifocal, moderate
Contributor's Comment:
The submitted ferret's presentation of acute non-ambulatory paraparesis and distended urinary bladder with large residual urine volume, along with reported neurolocalization, supported a T3-L3 myelopathy of unclear origin. Potential differentials for this ferret's clinical presentation of acute paresis included metabolic disease (i.e., insulinoma, hyperadrenocorticism, prolonged estrus), neoplasia (i.e., plasma cell tumor (solitary osseous plasmacytoma, multiple myeloma), lymphoma, chordoma, osteoma, osteosarcoma), Aleutian disease, intervertebral disc disease, vertebral congenital malformations, and primary myelitis.11 Autopsy confirmed a mass originating within the T11 vertebra associated with marked osteolysis and extension into the vertebral canal, as well as extension into the surrounding fibrous and adipose tissue stroma. Compressive myelopathy secondary to tumor growth was confirmed. Consistent with the antemortem abdominal ultrasound, the spleen was severely enlarged with multiple white foci and nodules. Microscopic examination confirmed a neoplastic population of plasma cells in both the vertebrae and spleen suggestive of multiple myeloma/plasma cell myeloma. After gross postmortem examination, findings of the previously submitted urine electrophoresis reported a relatively narrow, large peak in the beta fraction supportive of a possible monoclonal gammopathy. An additional finding in this patient of unclear clinical significance was a single pancreatic neuroendocrine tumor, which was confirmed as an insulinoma with immunohistochemistry for insulin.
Tumors originating from plasma cells include extramedullary plasmacytoma, solitary osseous plasmacytoma, and multiple myeloma (plasma cell myeloma). Plasmacytomas are the most common plasma cell tumors in dogs, and are described frequently in cats and uncommonly in other species.15,32 Plasmacytomas are typically solitary and are most commonly described in the skin/subcutis, oral cavity, gastrointestinal tract (particularly colorectal region), but can occur in any organ.7,9,18,24,30,32,33 Plasmacytomas are typically benign and surgical excision is generally considered curative.5,7,9,24,32,33 However, infrequent reports of plasmacytomas displaying relatively more aggressive behavior have been described in both dogs and cats.6,9,32 Cutaneous plasmacytomas over the face can display local tissue invasion, including into the underlying bone.33 Rare cases of plasmacytoma with associated monoclonal gammopathies are reported in dogs but multiple myeloma should be favored in cases of plasma cell tumor with monoclonal gammopathy.7,15,32 Solitary osseous plasmacytomas are rare neoplasia reported in people, dogs, and ferrets,15,25,29 and in humans may represent an early stage of multiple myeloma.22,25,29 Solitary osseous plasmacytomas represent lytic, locally destructive tumors affecting a single site and not associated with gammopathy,15,22,25,29 and have been reported in the vertebrae, jaw, carpus, long bones, and ribs of dogs.25 Multiple myeloma (plasma cell myeloma) is a rare neoplasm of malignant plasma cells arising in the bone marrow or extramedullary sites (i.e., spleen and liver) associated with hyperglobulinemia.5-8,14-16,20,23,26,29,31-33 Extramedullary site involvement is more common in the cat.13,29,32,33 The term myeloma-related diseases (MRD) has been adopted in humans and cats, to describe a group of plasma cell or immunoglobulin-secreting B-cell tumors, of which multiple myeloma is one.1,8,13,14,15,22,32 Multiple myeloma is more commonly reported in dogs and to a lesser extent in cats, including a non-domestic feline.6,7,13,20,24,26,29,32 Multiple myeloma represents approximately 0.3-1% and <1% of all malignancies in dogs and cats, respectively.1,6,7,14,21,23,26,29,31,34 Cases in other species (horses, cows, pigs, rabbits) are uncommon.5,7,12,20,23,24,32 Multiple myeloma is more common in middle aged to older animals1,5,16,22,23,26,29,34; however, an atypical presentation in three juvenile dogs have been reported.22,34 There is no breed or sex predilection in dogs.31,32 In cats, a male predominance has been reported.6,14,23,29 In dogs, altered cell cycle protein cyclin C expression may be associated with tumor development.32
A common, but not consistent, feature of multiple myeloma is the production of immunoglobulin (Ig) or Ig fragments (paraprotein or M-protein) leading to a gammopathy on electrophoresis, which is most typically monoclonal and less commonly bi-clonal.5-8,14,16,21-23,26,29,31-33,36 Light-chain fragments, unattached to heavy chain portions, are filterable though the glomeruli leading to Bence-Jones proteinuria.6-8,21,22,29,32 Evaluation of densitometric M-protein concentration can be used to evaluate response to therapy.21,22 Non-secretory myeloma, lacking a gammopathy, is seen in small percentage of cases.32,33 Other conditions that can be associated with monoclonal gammopathies include chronic infections (i.e., ehrlichiosis and other tick-borne disease, leishmaniasis, chronic pyoderma, and FIP) and other neoplastic processes (i.e., B-CLL, B-cell lymphoma).7,23,32-33 The most common clinical signs seen with multiple myeloma are non-specific and include pallor, lethargy, listlessness/weakness, inappetence, anorexia, weight loss, and intermittent vomiting.14,23,26,29 More specific clinical signs depend on distribution of bone lesions and visceral organ involvement, as well as the clinical ramifications of hyperglobulinemia and hypercalcemia. Pain and lameness are common complaints in dogs due to bone lesion(s).7,8,32,33 With vertebral column involvement, spinal pain, proprioceptive ataxia, paraplegia, and other neurologic manifestations can be seen.6,29,33,36 Osteolytic lesions are less common in cats.1,14,19,22,31,32 CBC and biochemical changes include anemia (most commonly non-regenerative, normocytic, normochromic), thrombocytopenia, various leukopenias, hypercalcemia (related to osteolysis and/or PTHrP production), hyperglobulinemia, hypoalbuminemia, hypercholesterolemia, elevated ALP, and azotemia.6,8,14,16,23,26,29,31-34,36 Circulating neoplastic cells are rarely reported with multiple myeloma.7,16,23,29,32 Thrombocytopenia, as well as altered platelet function due to paraproteins, can lead to bleeding diathesis.23,26,32,33 Precipitation of the paraprotein and immunoglobulins (cryoglobulinemia) at cold temperatures can lead to ischemia damage, as well as bleeding tendencies.7,28 Polyuria and polydipsia can be seen secondary to hypercalcemia, light-chain proteinuria, or amyloidosis.33 Associated disease manifestations attributed to hyperglobulinemia, paraproteinemia, and biochemical alterations include hyperviscosity syndrome, renal disease (including glomerulonephritis and nephrotic syndrome), light chain deposition disease, extra-tumoral amyloidosis, hypertension, heart failure, immunosuppression, and retinopathy or retinal hemorrhages. 5,7,14,19,23,26,28,29,31,32,36 Myelomatous pleural effusion is a rare clinical manifestation described in people and cats.1,14 When present,
osteolytic bone lesions tend to involve areas of active hematopoiesis.13,29 In small animals, the vertebra (particularly thoracolumbar), femur, pelvis, humerus, skull, and ribs are the most common sites.6,8,29,34 On imaging, bone lesions are classified most commonly as discrete, "punched out" lytic lesions, typically in multiple bones, with variable sclerotic margins and periosteal reactions.6,8,16,23,29 Less common imaging patterns include permeative lysis, small lytic foci, homogenous, soft tissue attenuating intramedullary masses, and generalized osteoporosis.8,29 Pathologic fractures can be seen.6- 8,14 In one case series of bone lesions of computed tomography (CT) in dogs, all the studied dogs had axial skeleton involvement and 69% had concurrent appendicular skeleton lesions.8
On gross examination of affected bones, the trabecular bone/medullary cavity are replaced and filled by a soft, fleshy to gelatinous, dark red to grey-pink nodules and masses.6,29 Histology shows focal or locally extensive solid tumors of densely packed neoplastic plasma cells arranged in sheets, cords, and packets that replace the hematopoietic cells and adipose tissue of the medullary cavity and are supported by a fine fibrous stoma.6,7,16,29,32 Cortical bone destruction with/or without local soft tissue invasion can be seen.29 Cellular features of plasma cell differentiation include round cells with moderate to large amounts of amphophilic to basophilic cytoplasm with perinuclear clearing (Golgi apparatus).7,9,16,18,22,30,32 Nuclei are paracentral to eccentrically placed with clumped chromatin that aggregate in the center or along the nuclear membrane ("clockface" pattern).7,9,16,18,22,32 Mott cells with prominent cytoplasmic vacuoles (Russel bodies) containing immunoglobulins and may result from altered intracellular protein transport.18,22,32 Due to differences in stain protocols, these vacuoles can range from semi-clear, to light blue, to pink.22,32 "Flame cells" are characterized by an outer rim of densely purple or eosinophilic cytoplasm,32 with light to bright pink projections/blebs or fringe due to accumulation of immunoglobulins.7,22,23,29 Less well-differentiated tumors display a wider range of cellular and nuclear pleomorphism, variable nuclear-to-cytoplasmic ratio, increased numbers of binucleate and multinucleated cells, and lack of Golgi perinuclear clearing.29,32 Plasma cell tumors infrequently have intratumoral light chain amyloid (AL-amyloid).6,7,18,19,22,24,30,32 Erythrophagocytic plasma cell tumors have been described.3,26 With less differentiated forms, immunohistochemistry (IHC) can be useful to rule-out other round cells tumors. In dogs, MUM1 is the most specific marker for plasma cell tumors.6,7,9,16,24,26,31-34 Multiple myeloma oncogene 1 (MUM1) is an interferon regulatory transcription factor involved in immunoglobulin light-chain re-arrangement and production of plasma cells.16,22,24,31,32 Additional tumors that can infrequently be immunoreactive to MUM1 include B-cell lymphoma and anaplastic lymphoma.24,32 Less consistently plasma cell tumors will stain with lambda and kappa light chains, Ig heavy chains, CD79a, and CD20.9,19,22,24,32,33 In one study of canine plasmacytomas, 93.5% of tumors were immunoreactive to MUM1, while only 56.2% and 19.4% of tumors were reactive with CD79a and CD20, respectively.24 In a case series in cats, 32% of MRDs were immunoreactive to CD79+.19 Methyl green pyronine histochemical stain inconsistently highlight plasma cells.9
Traditionally, the presence of multiple osteolytic lesions was strongly suggestive of multiple myeloma in dogs; however, disease manifestation in cats are different than those reported in both dogs and humans where cats with MRDs typically present with paraproteinemia and have less frequent bone marrow involvement.1,14,19,22,31,32 In two retrospective studies of MRDs in cats, only a percentage of cats displayed osteolytic lesions (58.3% of studied cats) or bone marrow plasmacytosis (63% of studied cats), and most cats had non-cutaneous, extramedullary plasma cell tumors, typically in the liver and/or spleen in those evaluated for them.14,23 Thus, extramedullary neoplastic transformation may be more common in cats with MRD than other species,1, 19, 22, 31 but it is unknown in feline MRD affecting both compartments concurrently arise initially in extramedullary sites with later bone marrow infiltration or extramedullary tumors represent metastases.14,19 Historically, the diagnostic criteria of multiple myeloma required the presence of two or more of the following features: 1) bone marrow with >20% of plasma cells, 2) osteolytic lesions, 3) serum or urine monoclonal gammopathy, and 4) light-chain proteinuria (Bence-Jones proteinuria).1,5,7,8,14,16,17,21-24,29,31,33,34,36 Recent studies show the diagnostic criteria of Bence-Jones proteinuria can be fulfilled by documenting free light-chains (fLCs) in urine and/or serum.8,22,34 Recently, the diagnostic criteria in humans has been updated to add weight to each criteria, as well as incorporate advanced imaging findings, signs of organ-damage, presence of "myeloma-defined events" (hypercalcemia, renal disease, anemia, and bone lysis), and biomarkers of malignancy; and in this updated criteria the threshold of plasmacytosis can be lowered to >10% depending on the clinical picture.22,23,28 Based on newer information, the threshold for plasmacytosis could be lowered (>10%) in feline cases with visceral organ involvement, presenting hyperglobulinemia or paraproteinemia, and with atypical plasma cell morphologies.1,14,16,23,29,33 In a retrospective study of multiple myeloma in 16 cats, bone marrow plasmacytosis, ranging from 13-99%, was present in 93.3% of the examined cats, and the majority of these cases (83.3%) had immature and atypical morphologies.23 The authors advocated for a modified diagnostic criteria in cats to include consideration of plasma cell morphology and visceral organ involvement.23 In a multi-institutional retrospective study of feline MRDs, of 17 cats with bone marrow involvement 64.7% of cats had plasmacytosis of >10% and 35.3% of cats had bone marrow plasmacytosis ranging from 5-10% with marked cytonuclear atypia.14 In this series, bone marrow plasmacytosis was rarely seen in cats without splenic or liver involvement (9% of the study population).14 The authors of this study emphasized the importance of extramedullary involvement and bone marrow cellular atypia as part of the criteria of diagnosis in cats, even when bone marrow plasmacytosis between 5-10%.14 Current recommendations in cats include at least two of the following: 1) >10% bone marrow plasmacytosis or >5% atypical plasma cells, 2) paraproteinemia, 3) osteolytic lesions, 4) light chain proteinuria, and 5) visceral organ involvement.14,23,33
The two most common neoplasms in domestic ferrets arise in the endocrine system (i.e., pancreatic neuroendocrine tumors and adrenal cortical tumors).2,27,35 The most common hematologic malignancy in ferrets is lymphoma, and spinal lymphoma can present with neurologic dysfunction similar to the submitted case.11,27,35 Chordomas are the most common neoplastic process in the musculoskeletal system of ferrets, they are low grade malignancies derived from the notochord and can be associated with locally destructive lesions in the vertebral body at any segment of the spinal column and be associated corresponding neurologic symptoms.27,35 Like the submitted case which had concurrent plasma cell tumors and insulinoma, multiple distinct, synchronous tumors are common in ferrets and up to 20% of ferrets are diagnosed with multiple simultaneous tumors.27 Like the submitted case, reports of malignant plasma cell tumors, including plasma cell myeloma/multiple myeloma, in ferrets are limited, but in reports hindlimb ataxia and paresis were common clinical complaints and association with vertebral bone tumors was confirmed in multiple cases.5,17,20,35 Plasma cell tumors have been reported in the bone (most commonly the vertebrae), spleen, liver, lymph node, as well as multicentric disease in ferrets.2,5,17,20 In addition, a case report of a solitary osseous plasmacytoma associated with secondary vertebral fracture and without gammopathy and extramedullary involvement has been reported in a ferret that presented with non-ambulatory paraparesis, decreased postural reactions, upper motor neuron bladder, and pain.15 In one case series of malignant plasma cells tumors in six ferrets, clinical signs included hindlimb ataxia and paresis (most common), urinary system signs (either primary or neurologic), and pain.5 Reported hematologic alterations were variable among the reported ferrets but included anemia, neutrophilia, leukocytopenia, hyperglobulinemia, hyperphosphatemia, hypoglycemia, and hypercalcemia; however, concurrent disease processes may have been a contributing factor in the study cohort (i.e., adrenal disease, inflammatory bowel disease, lymphoma, hemangiosarcoma, insulinoma).5 In this study population, hyperglobulinemia was most common and monoclonal gammopathy was confirmed in one ferret.5,35 At the time of diagnosis in this cohort, extramedullary disease was identified in 5/6 cases and dissemination to more than four locations was seen in majority of these.5 Based on this patient population, malignant plasma cell tumors are aggressive in ferrets and rapidly progressive with a median survival time of 107 days following diagnosis.5 In two single case reports of multiple myeloma/plasma cell myeloma in ferrets, a similar presentation of paraparesis and hind limb paralysis, related to vertebral plasma cells tumors were documented and one of these cases had confirmed extramedullary tumors including in the liver, spleen, lymph nodes, kidney, and thyroid glands.17,20
Contributing Institution:
Schwarzman Animal Medical Center 510 East 62nd St. New York, NY 10065 http://www.amcny.org
JPC Morphologic Diagnosis:
Vertebra, spinal canal, and epaxial musculature: Lymphoma.
JPC Comment:
Dr. Derron "Tony" Alves, a former Director of the JPC's Veterinary Pathology Service and retired U.S. Army colonel, moderated this year's 21st conference, providing participants with some fascinating lab animal case selections. This first case sparked an excellent discussion on species-specific pathology in ferrets. Ferrets are notorious for developing a variety of neoplasms, including islet cell tumors, adrenocortical tumors, and lymphoma, all of which should come to the top of the pathologist's mind when approaching ferret cases (especially in the age group of the ferret in this case. This case indeed had a concurrent insulinoma, highlighting the species' tendency toward multiple synchronous neoplasms.
Participants immediately recognized a round cell neoplasm replacing the vertebral marrow cavity. Because participants had only the H&E slide to review prior to conference, and because the neoplastic cells displayed atypia without uniformly classic plasma cell morphology, conference goers agreed that they could not definitively diagnose a plasma cell tumor from the slide alone. As such, the JPC elected to diagnose a lymphoma, which is reflected in the morphologic diagnosis. This decision also reflects the fact that, in addition to the morphology of the neoplastic round cells, lymphoma is the most common hematopoietic neoplasm, as the most common malignancy in ferrets (islet cell tumors, which rarely metastasize in this species, notwithstanding). However, when the full clinical, gross, and laboratory context was revealed, including vertebral osteolysis, splenic involvement, monoclonal gammopathy, classic cytologic findings, and systemic plasma cell proliferation, the case aligned well with multiple myeloma as the final diagnosis. This contrast between what can be stated from the H&E slide alone and what can be concluded from a more comprehensive data set provided an excellent teaching moment on the importance of a full diagnostic work-up in cases such as this.
Participants reviewed the different plasma cell tumors, including solitary osseous plasmacytoma. This form serves as a "between" diagnosis that is neither a benign cutaneous plasmacytoma nor a fully systemic multiple myeloma. Osseous plasmacytomas are typically single, isolated bone lesions without gammopathy or visceral involvement, which did not match the full case once ancillary findings were revealed.
The slide also contained several key osseous features, including resting and reversal lines, microfractures, reactive fibrosis, and numerous osteoclasts. All of these are consistent with an aggressive, lytic bone process. Although not present on the H&E slide, the contributor provided some excellent gross and additional histologic images that showed compression myelopathy of the affected area of thoracic spinal cord, serving as a correlation to the pathogenesis of the clinical presentation in this case.
The gross image of marked a markedly enlarged spleen with multifocal, pale tan nodules prompted a strong reminder from Dr. Alves that this pattern should raise suspicion for necrotizing splenitis across species lines. The marked splenic enlargement in this species is a common finding in older ferrets and typically associated with extramedullary hematopoesis (noted by the contributor in this case).
The group revisited the clinicopathologic hallmarks of multiple myeloma, which are covered in the contributor's excellent comment.14,23,33 One participant provided a fantastic reminder that globulins bind calcium in the blood and, when globulins are elevated, this can produce a falsely elevated total calcium on chemistry panels. An ionized calcium is required to confirm true hypercalcemia in such cases. Participants also reviewed other causes of increased gammaglobulins across species lines, such as ehrlichiosis, leishmaniasis, FIP, and chronic pyodermas.
Participants reviewed the different plasma cell tumors, including solitary osseous plasmacytoma. This form serves as a "between" diagnosis that is neither a benign cutaneous plasmacytoma nor a fully systemic multiple myeloma. Osseous plasmacytomas are typically single, isolated bone lesions without gammopathy or visceral involvement, which did not match the full case once ancillary findings were revealed.
The slide also contained several key osseous features, including resting and reversal lines, microfractures, reactive fibrosis, and numerous osteoclasts. All of these are consistent with an aggressive, lytic bone process. Although not present on the H&E slide, the contributor provided some excellent gross and additional histologic images that showed compression myelopathy of the affected area of thoracic spinal cord, serving as a correlation to the pathogenesis of the clinical presentation in this case.
The gross image of marked a markedly enlarged spleen with multifocal, pale tan nodules prompted a strong reminder from Dr. Alves that this pattern should raise suspicion for necrotizing splenitis across species lines. The marked splenic enlargement in this species is a common finding in older ferrets and typically associated with extramedullary hematopoesis (noted by the contributor in this case).
The group revisited the clinicopathologic hallmarks of multiple myeloma, which are covered in the contributor's excellent comment.14,23,33 One participant provided a fantastic reminder that globulins bind calcium in the blood and, when globulins are elevated, this can produce a falsely elevated total calcium on chemistry panels. An ionized calcium is required to confirm true hypercalcemia in such cases. Participants also reviewed other causes of increased gammaglobulins across species lines, such as ehrlichiosis, leishmaniasis, FIP, and chronic pyodermas.
References:
- Amalbert T, Canonne AM, and Beguin J. Myelomatous pleural effusion in a cat diagnosed with multiple myeloma. Journal of Feline Medicine and Surgery Open Reports. 2023;9(1):20551169221134094.
- Avallone G, Forlani A, Tecilla M, et al. Neoplastic diseases in the domestic ferret (Mustela putorius furos) in Italy: Classification and tissue distribution of 856 cases (2000-2010). BMC Veterinary Research. 2016;12:275.
- Barger AM, Skowronski MC, and MacNeill AL. Cytologic identification of erythrophagocytic neoplasms in dogs. Veterinary Clinical Pathology. 2012;41(4):587-589.
- Cantile C and Youssef S. Nervous System. In: Maxie MG, ed. Jubb, Kennedy and Palmer's Pathology of Domestic Animals. Vol 1. 6th ed. Philadelphia, PA: Elsevier Saunders; 2016:403.
- Clagett DO, Johnston MS, and Han S. Malignant plasma cell neoplasia in ferrets: A review of 6 cases. Journal of Exotic Pet Medicine. 2017;26:36-46.
- Craig LE, Dittmer KE, and Thompson KG. Bones and Joints. In: Maxie MG, ed. Jubb, Kennedy and Palmer's Pathology of Domestic Animals. Vol 1. 6th ed. Philadelphia, PA: Elsevier Saunders; 2016:123.
- Durham AC and Boes KM. Bone Marrow, Blood Cells, and the Lymphoid/Lymphatic System. In: Zachary JF and McGavin MD, eds. Pathologic Basis of Veterinary Disease. 7th eds. St Louis, MO: Elsevier. 2022;842-843,869.
- Harris RA, Miller M, Donaghy D, et al. Light chain myeloma and detection of free light chains in serum and urine of dogs and cats. JVIM. 2021;35:1031-1040.
- Hendrick MJ. Mesenchymal Tumors of the Skin and Soft Tissue. In: Mueten DJ, ed. Tumors in Domestic Animals. 5th ed. Ames, Iowa: John Wiley and Sons Inc; 2017:171-172.
- Hoim SE, Fitzgerald E, Mapletoft E, et al. Computed tomographic findings in dogs with multiple myeloma. Vet Med Sci. 2023;9:660-669.
- Ingrao JC, Eschar D, Vince A, et al. Focal Thoracolumbar spinal cord lymphosarcoma in a ferret (Mustela putorius furo). Can Vet J. 2014;55:667-671.
- Kameyama M, Ishikawa Y, Shibahara T, et al. Plasma cell myeloma producing IgG, IgM, and IgA immunoglobulins in a cow. JVDI. 2003;15:166-169.
- Kappeli U, Eulenberger U, Nitzl D, et al. Clinical challenge. Multiple myeloma. Journal of Zoo and Wildlife Medicine. 2009;40(4):398-401.
- Lecot L, Desmas-Bazelle I, Benjamin S, et al. Descriptive analysis and prognostic factors in cats with myeloma-related disorders: A multicenter retrospective study of 50 cases. JVIM. 2024;38:1693-1705.
- Liatis T, Gardini A, Marcal VS, et al. Surgical treatment of a vertebral fracture caused by osseous plasmacytoma in a domestic ferret (Mustela putorius furo). Journal of Exotic Pet Medicine. 2019;29:200-206
- Marchegiani A, Palumbo Piccionello A, Salvaggio A, et al. What Is Your Diagnosis? J Am Vet Med Assoc. 2016;249(1):47-9
- Marks AL, Gaschen L, Tully TN, et al. What is your diagnosis? Plasma cell neoplasia. J Am Vet Med Assoc. 2010;237(9):1033-4.
- Mauldin EA and Peters-Kennedy J. Integumentary System. In: Maxie MG, ed. Jubb, Kennedy and Palmer's Pathology of Domestic Animals. Vol 1. 6th ed. Philadelphia, PA: Elsevier Saunders; 2016:735.
- Mellor PJ, Haugland S, Smith KC, et al. Histopathologic, Immunohistochemical, and Cytologic Analysis of Feline Myeloma-Related Disorders: Further Evidence for Primary Extramedullary Development in the Cat. Vet Pathol. 2008;45:159-173.
- Reising AJ, Donnelly LL, RlesnerBK, et al. Solitary osseous plasmacytoma in dogs: 13 cases (2004-2019). JSAP. 2021;62:1114-1121.
- Romanelli P, Recordati C, Rigamonti P, et al. Erythrophagocytic multiple myeloma in a dog. JVDI. 2022;34(4):718-722.
- Schoemaker NJ. Ferret Oncology: Diseases, Diagnostics, and Therapeutics. Vet Clin Exot Anim. 2017;20:183-208.
- Spyropoulou M, Montanes-Sancho I, Gow AG, et al. Cryoglobulinemia associated with multiple myeloma in dog presenting with epistaxis and skin lesions. Veterinary Medicine and Science. 2024;10:e70084.
- Thompson KG and Dittmer KE. Tumors of Bone. In: Mueten DJ, ed. Tumors in Domestic Animals. 5th ed. Ames, Iowa: John Wiley and Sons Inc;2017:412-414.
- Uzal FA, Plattner BL, and Hostetter JM. Alimentary System. In: Maxie MG, ed. Jubb, Kennedy and Palmer's Pathology of Domestic Animals. Vol 2. 6th ed. Philadelphia, PA: Elsevier Saunders;2016:27-28.
- Valente PCLG, Peleteiro MC, Dias MJ, et al. Multiple myeloma in dogs: Use of the cell block technique as a new diagnostic tool. Vet Clin Pathol. 2024;53(1):93-98.
- Valli VE, Bienzle D, Meuten DJ, and Linder KE. Tumors of the Hemolymphatic System. In: Mueten DJ, ed. Tumors in Domestic Animals. 5th ed. Ames, Iowa: John Wiley and Sons Inc;2017:218-225.
- Valli VEO, Kiupel M, and Bienzle D. Hematopoietic System. In: Maxie MG, ed. Jubb, Kennedy and Palmer's Pathology of Domestic Animals. Vol 3. 6th ed. Philadelphia, PA: Elsevier Saunders;2016:137,226-228.
- Wachowiak IJ, Moore AR, Avery A, et al. Atypical multiple myeloma in 3 young dogs. Veterinary Pathology. 2022;59(5):787-791.
- Williams BH and Wyre NR. Neoplasia in Ferrets. Ferrets, Rabbits, and Rodents. 2020;92-108.
- Wyatt S, De Risio L, Driver C, et al. Neurologic signs and MRI findings in 12 dogs with multiple myeloma. Vet Radiol Ultrasound. 2019;60:409-415.